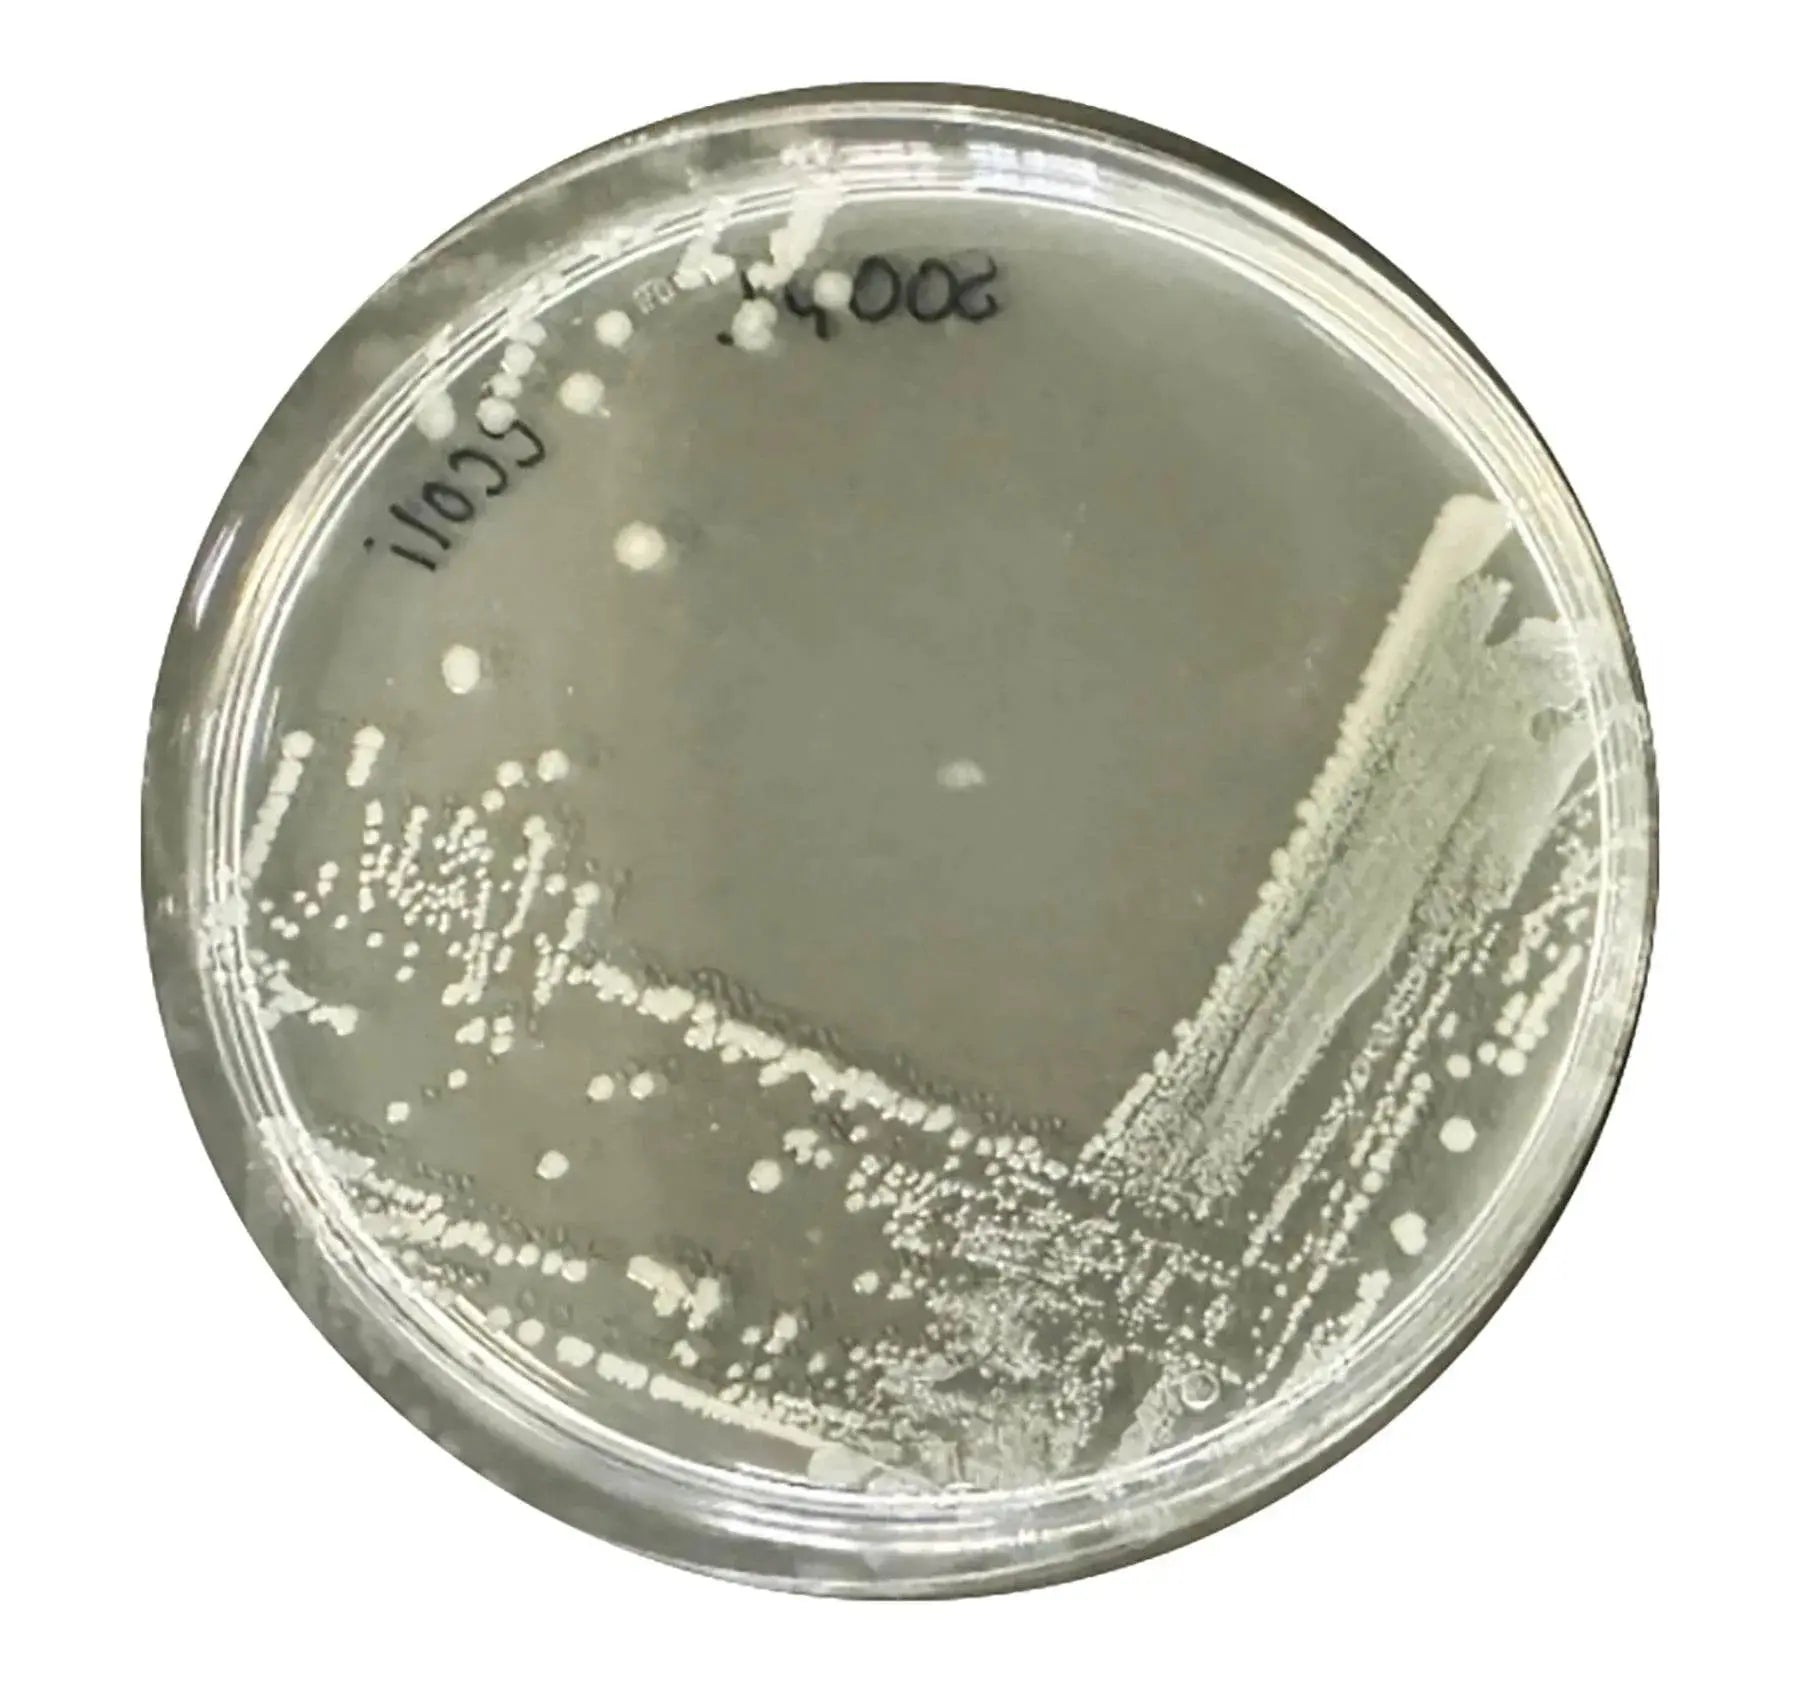
Identification and Characterization of Bacteria - Kormay Biomedicals store
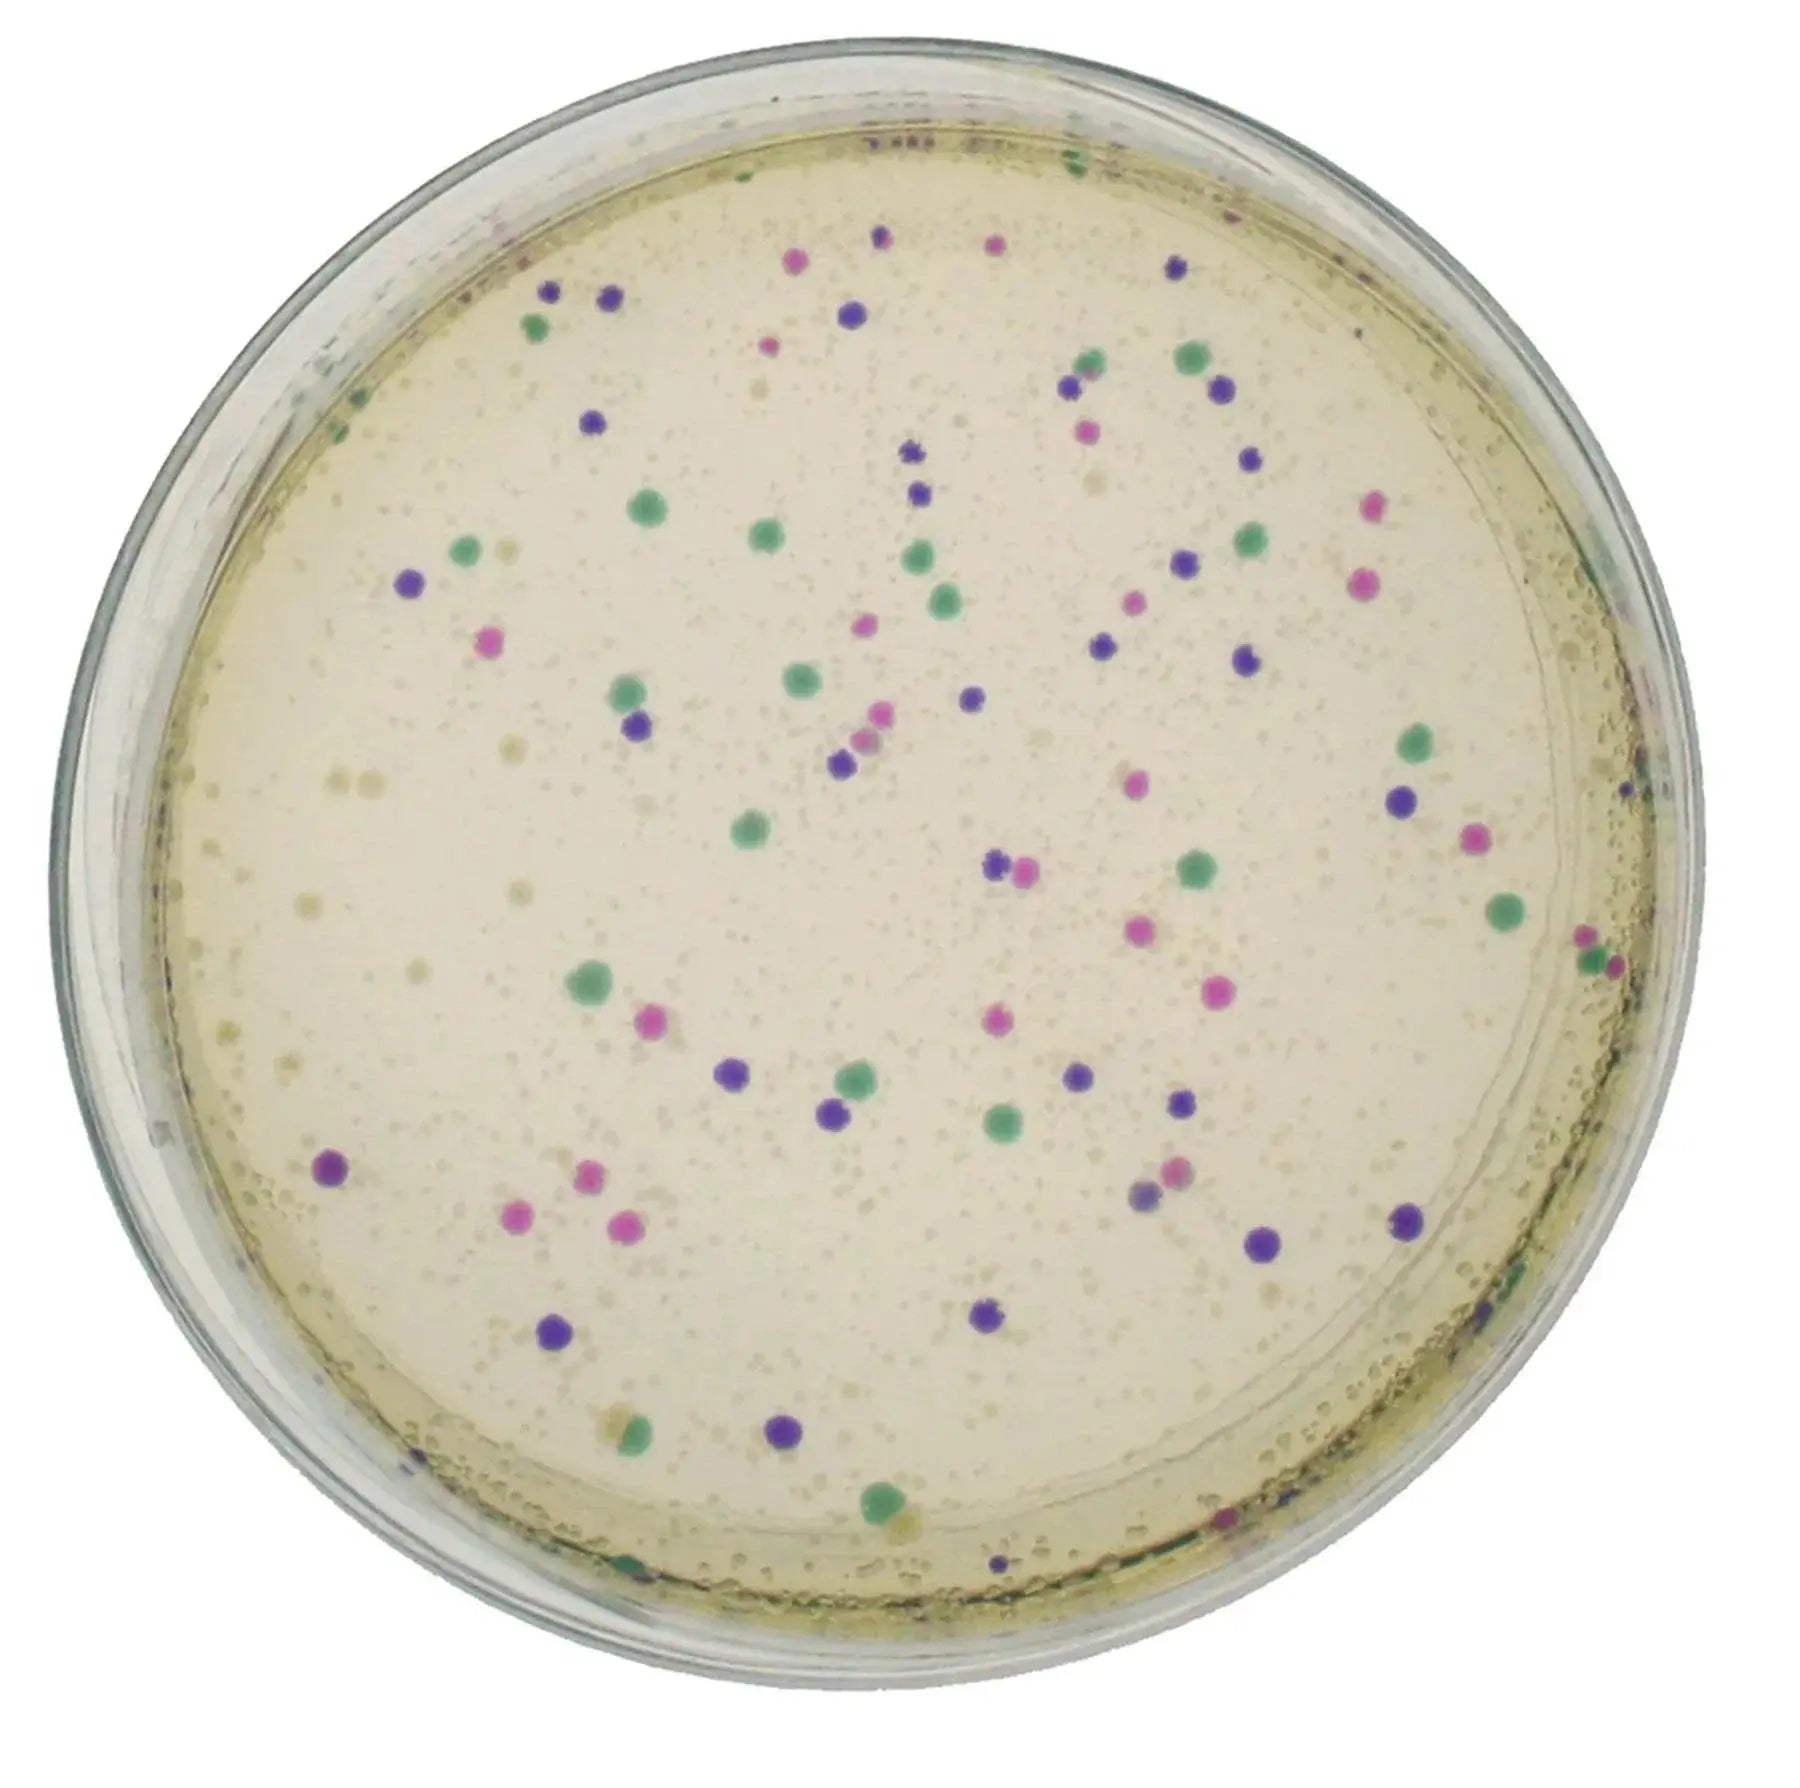
Rainbow Transformation - Kormay Biomedicals store

Featured product
View detailsPayments & Support
We accept major payment methods available, including credit cards and secure online payments.
Yes, you can contact us to request a customized quotation for bulk or specialized orders.
You can reach us through our contact page or email for assistance with products, orders, and technical inquiries.
Shipping
Yes, we ship to selected countries worldwide. Shipping costs vary depending on the destination, and we always strive to offer the most competitive rates. We also run promotions and special offers throughout the year. stay tuned for exclusive deals.
It depends on where you are. Orders processed here will take 5-7 business days to arrive. Overseas deliveries can take anywhere from 7-16 days. Delivery details will be provided in your confirmation email.
We use all major carriers, and local courier partners. You’ll be asked to select a delivery method during checkout.
Yes, we offer shipping across Canada with reliable delivery services.
Yes, bulk pricing and special quotations are available for businesses and institutions.
Product
We strive to ensure our customers are fully satisfied with our products. However, if you need to return an order, we’ll be happy to assist you in accordance with our return policy. Simply contact us by email, and our team will guide you through the process.
In most cases, changes are not possible. However, if the product includes multiple variants and you wish to adjust your selection, we’ll do our best to help you choose the option that best suits your needs.
If your product arrives damaged, please contact us immediately with photos, and we will assist with replacement or resolution.
General Questions
We supply microbiology culture media, laboratory consumables, food safety testing kits, biotechnology education kits, and physiotherapy equipment for professional and institutional use.
Our products are designed for laboratories, food production facilities, research institutions, Cosmetics labs, Water tests labs, schools, healthcare providers, and physiotherapy clinics.
Yes, many of our products meet internationally recognized quality standards, including ISO and CE certifications. Specific certifications may vary depending on the manufacturer and product type. For classified medical devices, all products we sell in Canada are fully compliant with Health Canada regulations.
We supply both businesses and individual customers, depending on the product category.
Any question?
If we still haven't answered your question, you can contact us below and we will get back to you as soon as possible.